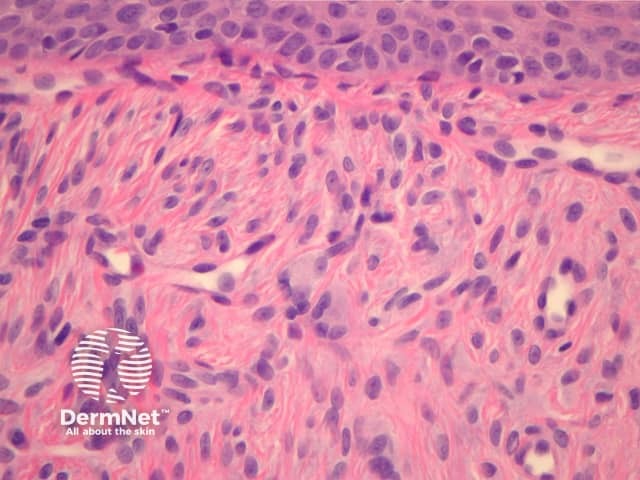
Figure 3

Main menu
Common skin conditions
NEWS
Join DermNet PRO
Read more
Quick links
Blood vessel problems Diagnosis and testing
Author: Assoc Prof Patrick Emanuel, Dermatopathologist, Auckland, New Zealand, 2013.
Introduction Histology Special studies Differential diagnoses
There are several distinct clinical forms of angiofibroma which share identical histopathology:
Angiofibromas cause a dome-shaped mass in the superficial dermis (figure 1). The overlying epidermis is uninvolved but may be atrophic. The lesion is characterized by a proliferation of stellate and spindled cells around blood vessels (figure 2). There are coarse concentric collagen bundles (figures 1, 2). Comparing the density of the collagen of the lesion with the surrounding dermis, which should be looser or elastotically damaged, can be a helpful diagnostic clue. Occasionally, a sparse inflammatory cell infiltrate of lymphocytes is present.
Several histological subtypes have been described:

Figure 1

Figure 2
Figure 3
Dermal dendritic cells usually stain for factor XIIIa. S100 is negative.
Sclerosing naevus — These usually do not exhibit vascular ectasia. S100 stain will highlight the melanocytes, and will be negative in fibrous papules.
Capillary haemangioma — These lack the fibrous stroma with stellate fibroblasts and dense collagen.